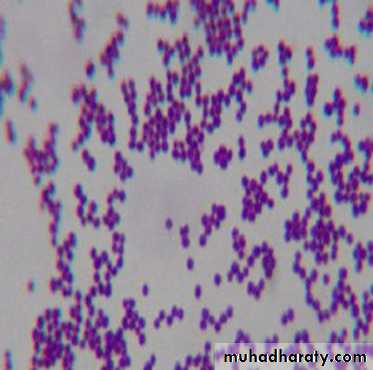

Lec.1
Dr.Sarmad Zeiny2013-2014
BCM
Lec.1
Dr.Sarmad Zeiny
2013-2014
BCM
GRAM-POSITIVE BACTERIA
Genus StaphylococcusObjectives: Upon completion of this lecture, the student will:
Outline the medically important staphylococci species.Describing the morphology & physiology for staphylococci.
Determine the virulence factors for staphylococci.
Analyze the diseases & pathogenicity for staphylococci.
Demonstrate the epidemiology/transmission for staphylococci.
Outline the laboratory diagnosis for staphylococci.
State the drug of choice and prophylaxis where regularly used.
Lec.1
Dr.Sarmad Zeiny
2013-2014
BCM
Lec.1
Dr.Sarmad Zeiny
2013-2014
BCM
GRAM-POSITIVE BACTERIA
Genus StaphylococcusThe 3 medical important species:
Staphylococcus aureus.
Staphylococcus epidermidis.
Staphylococcus saprophyticus.
Important Properties of genus staphylococcus:
The Shape: Staphylococci are spherical gram-positive cocci
Arrangement: arranged in irregular grapelike clusters (Figure 1).
Biochemically: All staphylococci produce catalase enzyme, whereas no streptococci do (catalase degrades H2O2 into O2 and H2O), Catalase is an important virulence factor because H2O2 is microbicidal and its degradation limits the ability of neutrophils to kill.
Fig.1
Fig.1
S.aureus is by far the most pathogenic species. S.aureus is distinguished from the others primarily by coagulase production, for that reason, S.aureus called coagulase positive staphylococcus. Coagulase is an enzyme that causes plasma to clot by activating prothrombin to form thrombin. Thrombin then catalyzes the activation of fibrinogen to form the fibrin clot.
S.epidermidis and S.saprophyticus are often referred to as coagulase-negative staphylococci.
All Staphylococci tolerate high salt concentration (up to 9.5% Nacl).
S.aureus produces a pigment called staphyloxanthin, which imparts a golden color to its colonies. This pigment enhances the pathogenicity of the organism by inactivating the microbicidal effect of superoxides and other reactive oxygen species within neutrophils.
Sta. aureus usually ferments mannitol and hemolyzes red blood cells, whereas the others do not.
S.saprophyticus resistant to novobiocin (type of antibiotic) while others are sensitive.
Staphylococci and streptococci are non-motile and do not form spores.
Staphylococcus aureus (Staphylococcus pyogenes):
Distinguishing Features:• Small, yellow colonies on blood agar.
• β – hemolytic on blood agar (complete destruction of RBC).• Coagulase positive (all other Staphylococcus species are negative).
• Ferments mannitol on mannitol salt agar.
Fig.2
Fig.2Fig. 2: Staphylococci lie in grape-like clusters as seen on Gram stain. Visualize this cluster of hospital staff posing for a group photo. Staphylococcus aureus is catalase-positive, thus explaining the cats in the group photo. Staphylococcus aureus (aureus means "gold") can be differentiated from the other beta-hemolytic cocci by their elaboration of a golden pigment when cultured on sheep blood agar. Notice that our hospital Staff (Staph) all proudly wear gold medals around their necks. Note how all the Gold-Medalists (Staphylococcus aureus) hang out together to show each other their gold medals. You can think of them as coagulating together.
Reservoir:
• Normal flora- Nasal mucosa (25% of population are carriers)
- Skin
Transmission:
• Hands• Sneezing
• Surgical wounds
• Contaminated food
- Custard pastries
- Potato salad
- Canned meats
Virulent factors and pathogenesis:
S.aureus has a microcapsule surrounding its huge peptidoglycan cell wall, which in turn surrounds a cell membrane containing penicillin binding protein (also called transpeptidase). Numerous powerful defensive and offensive protein weapons stick out of the microcapsule or can be excreted from the cytoplasm to wreak havoc on our bodies:Proteins That Disable Our Immune Defenses:
1) Protein A: This protein has sites that bind the Fc portion of IgG. This may protect the organism from opsonization and phagocytosis. See fig.3
2) Coagulase: This enzyme can lead to fibrin formation around the bacteria, protecting it from phagocytosis. See fig.3
3) Hemolysins (4 types): Alpha, beta, gamma, and delta. They destroy red blood cells, neutrophils, macrophages, and platelets. See fig.4
4) Leukocidins: They destroy leukocytes (white blood cells). See fig.4
5) Penicillinase: This is a secreted form of beta-lactamase. It disrupts the beta-lactam portion of the penicillin molecule, thereby inactivating the antibiotic.
6) Novel penicillin binding protein: This protein, also called transpeptidase, is necessary for cell wall peptidoglycan formation and is inhibited by penicillin. Some strains of Staphylococcus aureus have new penicillin binding proteins that are resistant to penicillinase - resistant penicillins and cephalosporins.
Fig. 3: Staphylococcus aureus wielding protein A and coagulase shields, defending itself from attacking antibodies and phagocytosis.
Fig. 3: Staphylococcus aureus wielding protein A and coagulase shields, defending itself from attacking antibodies and phagocytosis.
Fig.4: Luckless red blood cell following a neutrophil, running to destruction at the hands of Staphylococcus aureus and its hemolysis and leukocidin dynamite.
Fig.4: Luckless red blood cell following a neutrophil, running to destruction at the hands of Staphylococcus aureus and its hemolysis and leukocidin dynamite.
Proteins to Tunnel Through Tissue:
Hyaluronidase ("Spreading Factor"): This protein breaks down proteoglycans in connective tissue.Staphylokinase: This protein lyses formed fibrin clots (like streptokinase).
Lipase: This enzyme degrades fats and oils, which often accumulate on the surface of our body. This degradation facilitates Staphylococcus aureus colonization of sebaceous glands.
Protease: destroys tissue proteins. See fig.5
Fig.5: Staphylococcus aureus produces proteins that allow the bacteria to tunnel through tissue.
Fig.5: Staphylococcus aureus produces proteins that allow the bacteria to tunnel through tissue.
Fig.6: Staphylococcus aureus produces exotoxin assault weaponry.
Fig.6: Staphylococcus aureus produces exotoxin assault weaponry.Exotoxin Assault Weaponry: (see fig.6)
Exfoliatin: A diffusible exotoxin that causes the skin to slough off ( SSS “scalded skin syndrome”).Enterotoxins (heat stable): Exotoxins which cause food poisoning 2-6h after eating preformed toxin, resulting in vomiting and diarrhea. (See fig.7)
Toxic Shock Syndrome toxin (TSST-1): This exotoxin is analogous to the pyrogenic toxin produced by Lancefield group A beta-hemolytic streptococci, but is far more deadly. This exotoxin causes toxic shock syndrome and is found in 20% of S. aureus isolates. These pyrogenic toxins are called superantigens which bind to the MHC class II molecules on antigen presenting cells (such as macrophages). The toxin-MHC II complex causes a massive T cell response and outpouring of cytokines, resulting in the toxic shock syndrome described below. (See Fig.8).
Fig. 8: Toxic shock syndrome caused by Staphylococcus aureus releasing TSST-1.
Fig. 8: Toxic shock syndrome caused by Staphylococcus aureus releasing TSST-1.Fig.7: Staphylococcus aureus gastroenteritis. "I told you not to eat the mayonnaise, sweetheart!"
Fig.7: Staphylococcus aureus gastroenteritis. "I told you not to eat the mayonnaise, sweetheart!"
Diseases:
Disease caused by exotoxin release:1) Gastroenteritis (food poisoning).
2) Toxic shock syndrome.
3) Scalded skin syndrome(SSS).
Disease resulting from direct organ invasion: see fig.9
1) Pneumonia
2) Meningitis
3) Osteomyelitis (most common cause).
4) Acute bacterial endocarditis (rapid and destructive, emergency case)
5) Septic arthritis (most common cause in pediatric age and adult above 50, emergency case)
Fig.9: Diseases caused by direct organ invasion by Staphylococcus aureus. Visualize the Staph-wielding wizard. (Note the cluster of staphylococci at the head of his staff.)
Fig.9: Diseases caused by direct organ invasion by Staphylococcus aureus. Visualize the Staph-wielding wizard. (Note the cluster of staphylococci at the head of his staff.)
6) Skin infections (Folliculitis, Pustule, Boil (furuncle): e.g. Stye, Carbuncle, Impetigo, cellulites).
7) Bacteremia/sepsis
8) Urinary tract infection.
Predisposing Factors for Infection:
• Surgery/wounds• Foreign body (tampons, surgical packing, sutures)
• Severe neutropenia (<500/ µl)
• Intravenous drug abuse.
• Chronic granulomatous disease
• Cystic fibrosis
Staphylococcus aureus and antibiotics (very important):
More than 90% of Sta. aureus strains contain plasmids that encode β-lactamase (penicillinase), the enzyme that degrades many, but not all, penicillins. Rx. With β-lactamase–resistant penicillins, e.g., nafcillin or cloxacillin.Some strains of Sta. aureus are resistant to the β -lactamase–resistant penicillins, such as methicillin and nafcillin, by feature of changes in the penicillin-binding protein (PBP) in their cell membrane. Genes on the bacterial chromosome encode these altered PBPs. These strains are commonly known as methicillin-resistant Sta. aureus (MRSA) or nafcillin-resistant Sta. aureus (NRSA). MRSA currently accounts for more than 50% of Sta. aureus strains isolated from hospital patients in the United States Rx. With vancomycin.
Strains of Sta. aureus with intermediate resistance to vancomycin (VISA) and with full resistance to vancomycin (VRSA) have also been detected. The gene that encodes vancomycin resistance in Sta. aureus are located on a plasmid. MRSA, NRSA, VRSA & VISA can be treated with either Linezolid, quinupristin/dalfopristin or daptomycin.
Mupirocin is very effective as a topical antibiotic in skin infections caused by Sta. aureus. It has also been used to reduce nasal carriage of the organism in hospital personnel and in patients with recurrent staphylococcal infections.
S.aureus can resist antibiotics by:
β –lactamase production, encoded by plasmid.
Change in molecular structure of PBP, encoded by bacterial chromosome.
Resistant to Vancomycin, transmitted from other bacteria, encoded by plasmid.
Staphylococcus epidermidis (Staphylococcus albus):
Normal bacterial flora of the human skin.
It is coagulase-negative.
Infections are almost always hospital-acquired: compromised hospital patients with Foley urine catheters or intravenous lines can become infected when this organism migrates from the skin along the tubing.
Diseases: Infections of prosthetic devices in the body, such as prosthetic joints, prosthetic heart valves, CSF shunts, and peritoneal dialysis catheters. In fact, Staphylococcus epidermidis is the most frequent organism isolated from infected indwelling prosthetic devices.
The organisms have a polysaccharide capsule (slime layer) that allows adherence to these prosthetic materials.
Sta. epidermidis is highly antibiotic resistant. Most strains produce -lactamase and many are methicillin-/nafcillin-resistant due to altered penicillin-binding proteins. The drug of choice is vancomycin.
Staphylococcus saprophyticus
This organism is a leading cause (second only to E.coli) of urinary tract infections (UTI) in sexually active young women "Honeymoon cystitis".It is most commonly acquired by females in the community (NOT in the hospital).
This organism is coagulase-negative.
Urinary tract infections can be treated with a quinolone, such as norfloxacin, or with trimethoprim-sulfamethoxazole. See table1.
Laboratory features for genus Staphylococcus:
Slide: (microscopic characteristics) :A Gram’s stained film will shows spherical G+ve cocci arranged in grape like irregularCulture: (macroscopic characteristics):
Aerobic or facultatively anaerobic,Grow in ordinary media as (nutrient agar or blood agar).
Tolerate high salt conc. (9%NaCl).
The colonies are round, smooth, raised & glistening,
Producing pigments: S. epidermidis & S.saprophyticus white, S. aureus appear golden-yellow colonies.
Only S.aureus produces β-hemolysis, a zone of β-hemolysis will appear as clear zone around the colony on blood agar.
Only S.aureus can ferment mannitol.
The selective & differential medium used is called (Mannitol salt agar), this medium contain: Mannitol +7.5% NaCL + Phenol red (indicator), the pink color of the indicator turn to yellow because of mannitol fermentation & acid production (only by S.aureus), & the salt inhibit most other normal flora.
Steps of laboratory Diagnosis:
Specimens: according to type of infection, such as pus, blood, urine…etc.
Gram Stain: Gram’s positive cocci, Grape-like arrangement (clusters).Culture: on both
- Blood agar: see large, round, smooth, raised & glistening white or golden color, β-hemolysis if S.aureus.
- Mannitol Salt Agar: S.aurues: yellowish discoloration of media, other Staphylococci: no discoloration (remains pink media)
Biochemical tests:
a) Coagulase test: is recognized as the most important test for testing the virulence of S. aureus which is the only coagulase +ve staphylococci. So this test used to detect the ability of S. aureus to clot blood plasma (fibrinogen fibrin). There are two main methods: Slide method and tube method.
a) Catalase test: This is done to differentiate Staphylococci from Streptococci. A drop of 3% H2O2 solution placed on a slide, and a small amount of bacterial growth is in the solution placed on the slide, The formation of bubbles indicates a positive test of oxygen release.
Serological test: Latex agglutination test to detect S.aureus.
Antibiotic Sensitivity test.
For epidemiological purposes, Sta. aureus can be subdivided into subgroups based on the susceptibility of the clinical isolate to lysis by a variety of bacteriophages. A person carrying Sta. aureus of the same phage group as that which caused the outbreak may be the source of the infections.
Prevention: (very important):
There is no vaccine against staphylococci.Cleanliness, frequent hand washing, and aseptic management of lesions help to control spread of Sta. aureus.
Persistent colonization of the nose by Sta. aureus can be reduced by intranasal mupirocin or by oral antibiotics, such as ciprofloxacin or trimethoprim-sulfamethoxazole, but is difficult to eliminate completely.
Shedders may have to be removed from high-risk areas, e.g., operating rooms and newborn nurseries.
Cefazolin is often used perioperatively to prevent staphylococcal surgical-wound infections.
Table 1: summarized the points of differences between 3 medically important Staphylococci species
Table 1: summarized the points of differences between 3 medically important Staphylococci species
It is extremely important to know how to differentiate staphylococci from streptococci because most staphylococci are penicillin G resistant.
Both staphylococci and streptococci are gram-positive cocci, but they are distinguished by two main criteria:
Microscopically, staphylococci appear in grapelike clusters, whereas streptococci are in chains.
Biochemically, staphylococci produce catalase (i.e., they degrade hydrogen peroxide), whereas streptococci do not.
Summary:
S.aureus is the most pathogenic species because of their virulent factors.
S.aureus colonizes nasal mucosa (25% of population are carriers).
Staphylococci easily diagnosed in the lab. By using Gram’s staining, culture and biochemical tests.
S.aureus and S.epidermidis are highly antibiotic resistance and causing nasty hospital acquired infections.
Staphylococci infection can be prevented by regular hygiene precautions and by antibiotics, no vaccine.
References:
Review of Medical Microbiology and Immunology11th edition 2010.Clinical Microbiology Made Ridiculously Simple, 6th ed, 2014.
Baily & Scott diagnostic microbiology, 12th ed.
END